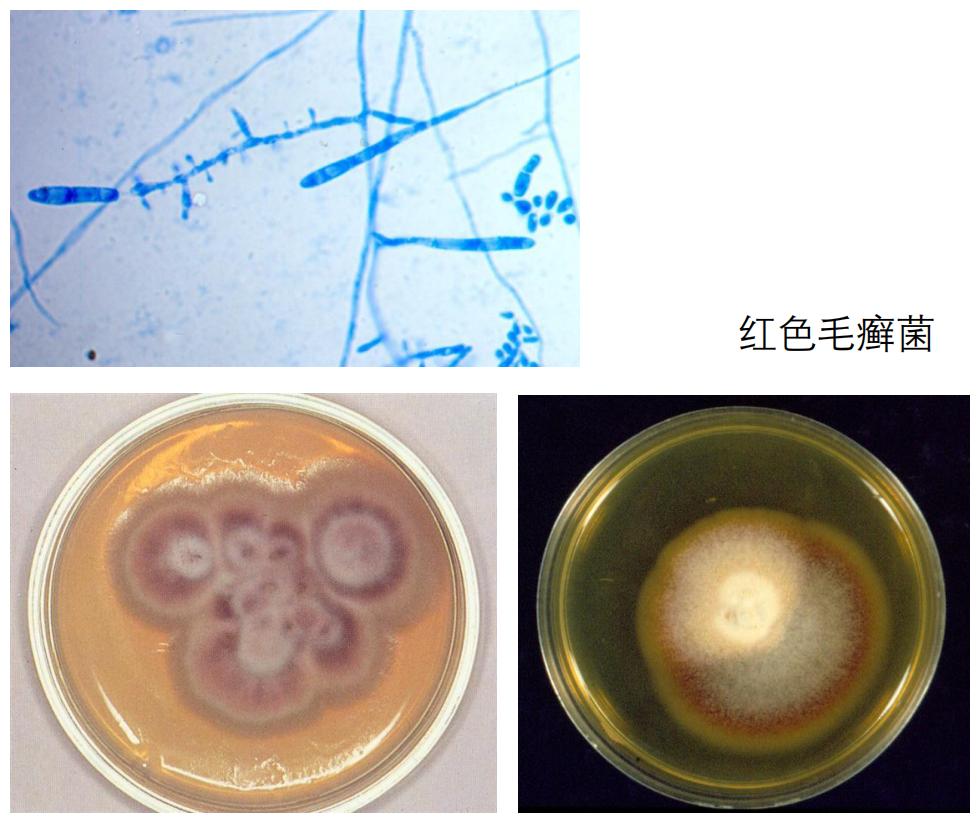
家里治脚气最好的方法,家庭治脚气的最好方法

大家好,我是空军总医院皮肤科王瑞艳。
最近,我有一位男患者来看病,妻子在一旁陪着。
当我确认这名男士患了脚气(足癣),嘱咐他这个病会传染时,他的妻子在旁突然问道:“医生,我下身痒是否是因为传染呀?”
果然,我一查,妻子有股癣。
我立刻让妻子再去妇科查一遍,果然,霉菌性阴道炎。
这就是脚气的恐怖,一人得病,全家遭殃。

脚气,比你想象的更可怕
大部分人对脚气的第一反应是啥?
害!不就是穿透灵魂的臭嘛!
但其实不止如此,脚气就还有诸如瘙痒、疼痛等症状。
而在搔抓导致进一步感染后,脚气就有可能会诱发淋巴管炎、下肢丹毒甚至败血症。
严重的时候,你可能连路都走不了。

(足癣引起丹毒,患者出现高热,足背出现疼痛性水肿性红斑)
大家都知道脚气能传染,但是你更要知道,这个传染并不是只有脚气传脚气。
如果一个脚气患者慢慢患上股癣、体癣、灰指甲,我是一点也不意外,这些病跟脚气一脉相承,大家都是真菌引起的,互相都要叫一声学长学妹。
你扣完脚的手又去挠了挠大腿内侧,哎,股癣达成,挠挠身体,恭喜你解锁体癣。

(体癣,来自网络)
这还只是自体传染,人传人更让人防不胜防。
作为脚气患者的家属,往往在被毒气笼罩的同时,还会有被传染的风险。
我列了一下,你能被脚气患者传染什么病:

如果这个脚气患者还是一个泡澡爱好者或者游泳爱好者,澡堂和泳池的朋友们就要保重了。
哦对了,忘了说,中国有50%以上的人有脚气,一个人一生脚气发病率在80%以上。
澡堂和泳池的朋友们,你们坚持住。

脚气患者一般以青年男性为主,男人们往往不太在意这些东西。
大丈夫不拘小节,脚臭点很正常,你懂个什么,这叫男人味。
听到这种话你有啥办法,只能一抱拳:铁血真汉子,很man很man。
眼睁睁看着他传染给一家老小。

最容易忽视的脚气
有的脚气就很奇怪,它不太一样。
我就有这么一个患者,她最开始的时候几乎没什么症状。
脚也不臭,甚至洗完澡还能萦绕一股幽香;
感觉整个脚不疼也不痒,还能去做个俩小时足疗;
唯一的症状就是脚后跟脱屑。
脚后跟脱屑多常见啊,一大把人换新鞋能把脚后跟磨出血,这简简单单脱皮脱屑压根不会引人注目。
我告诉你,最怕的就是这种容易被忽视的脚气。
脚气可以分作三种类型。
第一种是趾间糜烂型脚气,以脚趾间皮肤的糜烂和溃疡为主要症状,同时伴有脚汗多,脚臭脚痒,蜕皮等症状。

(这里放一个轻症的图,重症图有点恶心就不放了)
第二种是水疱型脚气,以足缘和足底的水疱为主要症状,奇痒无比。

(水泡型脚气)
上述这两种脚气都挺容易察觉的,毕竟就算你能忍得了脚臭,你也忍不了这疯狂的痒。
而第三种脚气就是刚刚提到的容易被忽略的脚气:鳞屑角化型脚气。
这种脚气以足缘、足底、脚跟皮肤变得粗糙和脱屑为主要症状,严重时会皲裂渗血。

(鳞屑角化型脚气)
刚刚提到的那名患者,患脚气的时候毫无知觉,尽管她的脚已经这样了:

(病人的角化型脚气)
但看似平静的表面下,却暗藏杀机,真菌已经慢慢侵犯到趾甲了。

(病人的甲癣,也就是灰指甲)
就有这么一天,这个患者突然感觉脚趾疼,来医院一检查,哦豁,感染了。

(甲周感染)
脚气不可怕,怕的是这种沉得住气的脚气,卧薪尝胆,三千越甲可吞吴。

脚气的好兄弟:灰指甲(甲癣)
有一个熟悉的病,其实跟脚气息息相关。
这就是灰指甲。
“得了灰指甲,一个传染俩”这样算一个*脑洗**广告。
在懂一点广告知识后,你会推算出一件事:能有钱持续在电视上投放广告,证明真的很多人得灰指甲。
是的,综合来看,我国有23.2%的人有灰指甲,平均5个人就会有一个灰指甲患者。
而这个比例,在脚气患者中是41%,也就是说5个脚气患者中,就有2个灰指甲患者。
所以脚气和灰指甲是好兄弟嘛。

(典型的灰指甲,医学上叫做甲癣)
脚癣直接传染,是灰指甲主要的发病原因。
但灰指甲还有一种很容易被忽略的发病原因:外伤。
所以,爱运动的男孩子要注意了,现在正值盛夏,现在的你们基本上具备了所有脚气和灰指甲的发病条件:
1)容易出汗,给了真菌相当良好的酸碱环境和湿度环境;
2)容易受伤,给了灰指甲的可乘之机;
3)铁血真汉子,容易忽视微小的症状,导致病情加重。

(我最近的一个灰指甲病人)
提到灰指甲,不得不说到跟治痘痘很类似的一个场景:
长痘的患者,往往不觉得是生病,喜欢去美容院祛痘;
灰指甲的患者,往往也不觉得是生病,喜欢去修脚店处理。
这就给了病菌可乘之机,病情就容易越来越严重。
灰指甲跟痘痘一样,都属于皮肤病,请来医院看皮肤科医生。

如何正确的预防脚气
如果不想跟脚气和灰指甲扯上关系,我们需要做好预防。
1.保持脚部干燥
既然脚气是由真菌引起的,我们就要想方设法阻止真菌的生长。
真菌大家应该很熟悉啊,蘑菇啊木耳啊这类就是典型的真菌。
嗯……所以你可以这样认为脚气是脚上长蘑菇了。
大家可以想一想,你们见到的蘑菇一般会生长在哪里?
潮湿的青石板是不是?
脚气同理,这些真菌也会喜欢容易出汗的地方。
因此,我们需要保持脚部的干燥,你可以通过这些手段来做:
1)穿透气不闷热的鞋子
2)穿透气的纯棉袜
3)多洗脚并且每次洗脚后把脚擦干
2.勤换鞋袜注意卫生
当然,在炎热的夏天你很难随时保持脚部干燥。
为了不让脚上的蘑菇长出来,我们还需要注意卫生,穿了两天的袜子比穿一天的袜子更容易长蘑菇。
袜子建议每天更换,并且与其他衣物分开洗,*裤内**同理。
3.注意阻断传播途径
防人之心不可无,尽量避免被传染也是很重要的。
你可以这样做:
1)不穿他人的鞋袜
2)不与他人共用脚盆、浴盆和毛巾
同时,如果你的家人有脚气,哪怕一哭二闹三上吊也要让他们来医院治疗。
当然,如果实在抽不出时间来医院,线上问诊也是可以的。
那么,线上问诊有哪些注意事项呢?
- 提供详细的病史
病史非常重要,你需要准备以下问题:
年龄?
性别?
多长时间了?
有脱皮吗?
有无水泡?
是否很痒?
有无脚臭?
有无夏天重、冬天轻的规律?
用过什么药,用药后有无缓解?
有无灰指甲、手癣?
有无糖尿病、高血压?
- 拍摄符合规范的照片
皮肤科医生需要这些角度的照片:双脚正面、双脚趾间、双脚足底、双脚内外侧缘

- 建议去医院做真菌检查
皮肤科医生也是靠真菌检查诊断的,有检查报告非常重要。
关注本公众号后,回复【好大夫】即可开始网上问诊。

写在最后
其实脚气这个病在皮肤圈的地位很高,1998年的时候,中华医学会皮肤性病学会工会就开始主办每年的“护足周”。
2020年的护足周就是现在,6月13日~6月19日。
作为一名皮肤科医生,我衷心地希望大家可以通过这篇文章来了解脚气给自己,给他人带来的危害。
我发现很多人认为脚气和灰指甲治不了,于是压根儿不去医院,事实上,脚气和灰指甲都是可以治疗的,如果自己有脚气,看到这篇文章后请赶紧去医院治疗。
正常来说1个月左右脚气就可以治好,灰指甲在规律治疗下,3~6个月可以治愈。
如果自己的朋友有脚气,可以把文章转到朋友圈,委婉地让他们看到。
功德无量。